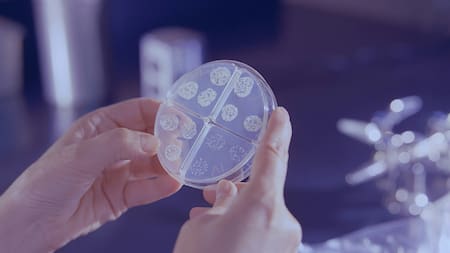
Bacterias. Foto: Unsplash

Piel sana: cuáles son las 2 partes del cuerpo que acumulan más gérmenes y bacterias
La alimentación, la actividad física, el consumo de alcohol y el tabaquismo son pilares fundamentales en lo que respecta a la salud; pero no los únicos. Según una reciente investigación, hay zonas del cuerpo que acumulan gérmenes y bacterias nocivas, afectando negativamente el microbioma cutáneo. ¿Cuáles son?
El equipo científico del Instituto de Biología Computacional de la Universidad George Washington, descubrió que frotarse detrás de las orejas y entre los dedos de los pies es una manera sencilla y eficaz de mantener la piel saludable.

Bacterias. Foto: Unsplash
El consejo de la abuela, punto de partida de la investigación
La piel es el órgano más grande del cuerpo y desempeña un papel fundamental en el bienestar del organismo, debido a que actúa como barrera. Sin embargo, para que la piel funcione de forma óptima es necesario controlar los microorganismos que allí habitan.
También podría interesarte
Los investigadores estudiaron el microbioma cutáneo, demostrando que su composición varía en las regiones seca, húmeda y grasa de la piel.

Piel. Foto: Unsplash
Keith Crandall, el líder de la universidad que supervisaba el estudio, tomó como punto de partida un consejo de higiene que le daba su abuela, quien enfatizaba la importancia de limpiar minuciosamente áreas como detrás de las orejas y entre los dedos de los pies.
La investigación
Para realizar la investigación, el equipo recolectó muestras de diferentes partes del cuerpo de 129 estudiantes y comparó el microbioma de las áreas limpiadas con frecuencia con las áreas que no estaban tan limpias.
Los resultados fueron impactantes: las áreas higienizadas correctamente tuvieron mayor diversidad de microbiomas y una presencia de bacterias más saludables en comparación con las secciones descuidadas.
Las áreas de piel seca, como los antebrazos y las pantorrillas, mostraron ser más equilibradas y ricas en diversidad funcional en comparación con las zonas sebáceas, como detrás de las orejas y las áreas húmedas como el ombligo y entre los dedos de los pies.

Orejas. Foto: Unsplash
El anuncio oficial de la Universidad destacó que la prevalencia de ciertos microorganismos problemáticos en el microbioma podría tener implicaciones para la salud. De hecho, un desequilibrio hacia microbios dañinos podría desencadenar enfermedades de la piel.
Cuidados para tener una piel sana
Los especialistas del sitio Mayo Clinic recomiendan tener los siguientes cuidados para mantener una piel sana:
- Cuidarse del sol: la exposición al sol provoca arrugas, manchas de la edad y otros problemas de la piel, así como un aumento del riesgo de contraer enfermedades como el cáncer de piel.
- Prohibido fumar: el tabaquismo genera en la piel un aspecto avejentado y contribuye a la formación de arrugas
- Cosmética adecuada: los jabones y detergentes fuertes pueden eliminar los aceites naturales de la piel. Para proteger y lubricar la piel hay que aplicar crema o loción al afeitarte.
- Dieta saludable: ciertas investigaciones sugieren que una dieta con alto contenido de aceite de pescado y baja en carbohidratos procesados mantiene la piel más joven.



















